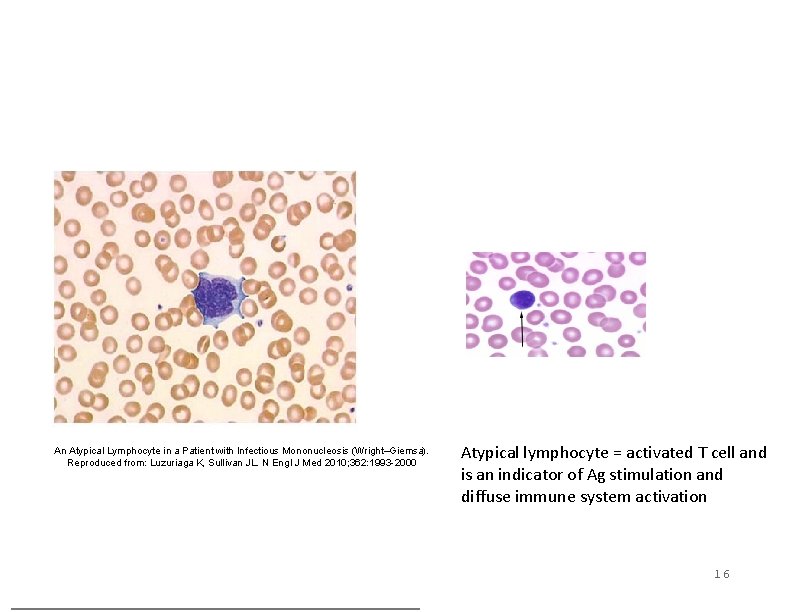
An Atypical Lymphocyte in a Patient with Infectious Mononucleosis (Wright–Giemsa). Reproduced from: Luzuriaga K, An Atypical Lymphocyte in a Patient with Infectious Mononucleosis (Wright–Giemsa). Reproduced from: Luzuriaga K,

Infectious mononucleosis Practical considerations and evidenceinformed management Evelyn

- Slides: 36
Infectious mononucleosis: Practical considerations and evidence-informed management Evelyn Wiener, MD Executive Director Student Health Service University of Pennsylvania Samuel L. Seward, Jr. , MD Associate Vice President/Medical Director Columbia Health Columbia University 1
I have no actual or potential conflict of interest in relation to this educational activity or presentation. 2
Objectives 1. Review the pathophysiology of infectious mononucelosis (IM) 2. Describe typical presentation and natural history of (IM) 3. Review atypical presentations of IM 4. Review diagnostic tests 5. Review management of student with IM, including early recognition of serious complications 3
1 st Virus-Cancer Association Sir Anthony Epstein Yvonne Barr Burt Achong 4
• • • Gamma herpesvirus Large Stable Double-stranded DNA Co-evolution with us Replication cycle: − Entry into memory B Cell − Lytic replication − Latency Simplified diagram of the structure of EBV. Reproduced from: http: //en. wikipedia. org/wiki/File: Viral_Tegument. svg 5
Main Target = Memory B Cells (up to 20%) CD 21 = entry receptor 6
Infection is complex immunological phenomenon Lytic phase = immunodysregulation; robust CD 8 T-cell response Odumade O A et al. Clin. Microbiol. Rev. 2011; 24: 193 -209 Latency = programmed hiding from normal immunosurveilance; down-regulation of normal protein expression 7
Natural History of EBV Infection q Primary EBV infection with containment: 1. Asymptomatic infection (common in children with naturally lower populations of memory B cells) 2. Acute IM (adolescents) 3. Recurrent infection/reactivation q Primary EBV infection with loss of containment: 1. Chronic active infection 2. Lymphoproliferative disorders (e. g. , in the setting of XLP or organ transplantation) 3. Malignancy q Relationship between EBV and Chronic Fatigue Syndrome? 8
Chronic fatigue syndrome after infectious mononucleosis in adolescents. Katz BZ, et al. Pediatrics. 2009; 124(1): 189. METHODS: A total of 301 adolescents (12 -18 years of age) with infectious mononucleosis were identified and screened for non-recovery 6 months after infectious mononucleosis by using a telephone screening interview. Non-recovered adolescents underwent a medical evaluation, with follow-up screening 12 and 24 months after infectious mononucleosis. After blind review, final diagnoses of chronic fatigue syndrome at 6, 12, and 24 months were made by using established pediatric criteria. RESULTS: Six, 12, and 24 months after infectious mononucleosis, 13%, 7%, and 4% of adolescents, respectively, met the criteria for chronic fatigue syndrome. All 13 adolescents with chronic fatigue syndrome 24 months after infectious mononucleosis were female and, on average, they reported greater fatigue severity at 12 months. 9
Risk Factors Risk factors: • Physical intimacy • Deep kissing 10
Adolescents naturally have larger memory B cell population Greater number of B cells infected more robust cytokine cascade, etc. and more symptomatic patient w/Ampicillin: 95 -100% w/o: 5 -15% 1 1
Diagnosis 12
Diagnostic tests Viral cultures CBC w/differential (most common: lymphocytosis) Heterophile antibody EBV titers EBV PCR Other viral serologies LFTs Radiography (neck films, U/S) 13
Sensitivity and specificity In the presence of IM symptoms, a positive heterophile antibody test: has a sensitivity of 85% and a specificity of 94% Source: Brigden ML, et al, Infectious mononucleosis in an outpatient population: diagnostic utility of 2 automated hematology analyzers and the sensitivity and specificity of Hoagland's criteria in heterophile-positive patients. Arch Pathol Lab Med. 1999; 123(10): 875 14
1 5
An Atypical Lymphocyte in a Patient with Infectious Mononucleosis (Wright–Giemsa). Reproduced from: Luzuriaga K, Sullivan JL. N Engl J Med 2010; 362: 1993 -2000 Atypical lymphocyte = activated T cell and is an indicator of Ag stimulation and diffuse immune system activation 16
Splenomegaly http: //www. youtube. com/watch? v=u 0 ozq. FNCHKU 1 7
Imaging 1 8
Heterophile-negative IM Approximately 10 percent of mono-like cases are not caused by EBV. Other infectious agents that produce a similar clinical syndrome include: CMV HIV Toxoplasmosis Human herpesvirus type 6 (HHV-6) Hepatitis B ? HHV-7 19
Differential Diagnosis of Pharyngitis. Reproduced from: Luzuriaga K, Sullivan JL. N Engl J Med 2010; 362: 19932000 20
Chronic active infection • Persistent (sometimes severe) IM-like symptoms w/ : o prolonged active viremia (ds. DNA and very high anti-EBV Ab titers) o Infection of other immune populations (Tcells and NK cells) • Fever, adenopathy, hepatosplenomegaly, fatigue, encephalitis • More common in children, Japan • LFT and hematologic abnormalities, including signs of hepatic failure • ~transformation into hemophagocytic lymphohistiocytosis 21
Lymphoproliferative Disorders 1) Hemophagocytic lymphohistiocytosis 2) Lymphomatoid granulomatosis 3) X-linked lymphoproliferative disease 4) Post-transplant lymphoproliferative disease Hallmark: absence of normal T cell response (Treatment #4: infusion of EBV-specific T cells) 22
2 3
Malignancies 1) Burkitt lymphoma • Endemic (100% = EBV-related) • Sporadic (40%) 2) Nasopharyngeal carcinoma 3) Hodgkin lymphoma 24
2 5
Age-specific distribution of EBV antibody positive individuals in four populations. Reproduced from de The et al. , 1975; Henle and Henle, 1967; Melbye et al. , 1984. From: Chapter 53, The epidemiology of EBV and its association with malignant disease Human Herpesviruses: Biology, Therapy, and Immunoprophylaxis. Arvin A, Campadelli-Fiume G, Mocarski E, et al. , editors. Cambridge: Cambridge University Press; 2007. 2 6
Serology of Epstein-Barr virus infection Alnoln Levels of Antibodies Specific to Epstein–Barr Virus (EBV) during Infectious Mononucleosis and Convalescence. EBNA denotes EBV nuclear antigen, and VCA viral capsid antigens. Reproduced from: Luzuriaga K, Sullivan JL. N Engl J Med 2010; 362: 1993 -2000 27
Management In most cases is supportive only…. 28
Acyclovir? Acyclovir = a nucleoside analogue that inhibits permissive EBV infection through inhibition of EBV DNA-polymerase but has no effect on latent infection or ability to cure the infection. Tx of acute EBV infections with intravenous and oral formulations has been studied. Shortterm suppression of oral viral shedding was shown, but significant clinical benefit was not. 29
From: Infectious Mononucleosis and Corticosteroids: Management Practices and Outcomes Arch Otolaryngol Head Neck Surg. 2005; 131(10): 900 -904. doi: 10. 1001/archotol. 131. 10. 900 Figure Legend: The overwhelming majority of patients given corticosteroids received them for indications other than the classically accepted airway concerns and idiopathic thrombocytopenic purpura (ITP). Date of download: 5/14/2014 Copyright © 2014 American Medical Association. All rights reserved. 3 0
Cochrane Review: steroids for pharyngitis Endpoint: complete pain resolution (CPR) 8 trials: 743 participants (369 adults) ALL patients given Abx + steroids (IM or PO) +/- analgesics Results: steroids were beneficial: At 24 hours Likelihood of Complete Pain Resolution 3 x control RR 3. 2 P value <0. 001 NNT <4 31
Cochrane Review: steroids for IM Endpoint: symptom control 7 trials but heterogeneity precluded combined analysis 2 trials showed benefit at 12 hours…but benefit not maintained Results: inconclusive evidence to support Tx 32
Return to school No restrictions When they are ready 33
3 4
Return to Play After Infectious Mononucleosis Jonathan A. Becker, MD et al, Sports Health, 2014. Evidence Acquisition: Pub. Med and MEDLINE database search through December 2012 by searching for epidemiology, diagnosis, clinical manifestations, management, and the role of the spleen in infectious mononucleosis. Results: Infectious mononucleosis is commonly encountered in young athletes. Its disease pattern is variable. Supportive care is the cornerstone, with little role for medications such as corticosteroids. Exercise does not appear to place the young athlete at risk for chronic fatigue, but determining who is at risk for persistent symptoms is a challenge. Conclusion: Return-to-play decisions for the athlete with infectious mononucleosis need to be individualized because of the variable disease course and lack of evidence-based guidelines. 3 5
Prognosis Vast majority of individuals with primary EBV infection recover uneventfully and develop durable immunity controlling the latent virus. Most acute symptoms resolve in one to two weeks, although fatigue and poor functional status can persist for months. 3 6